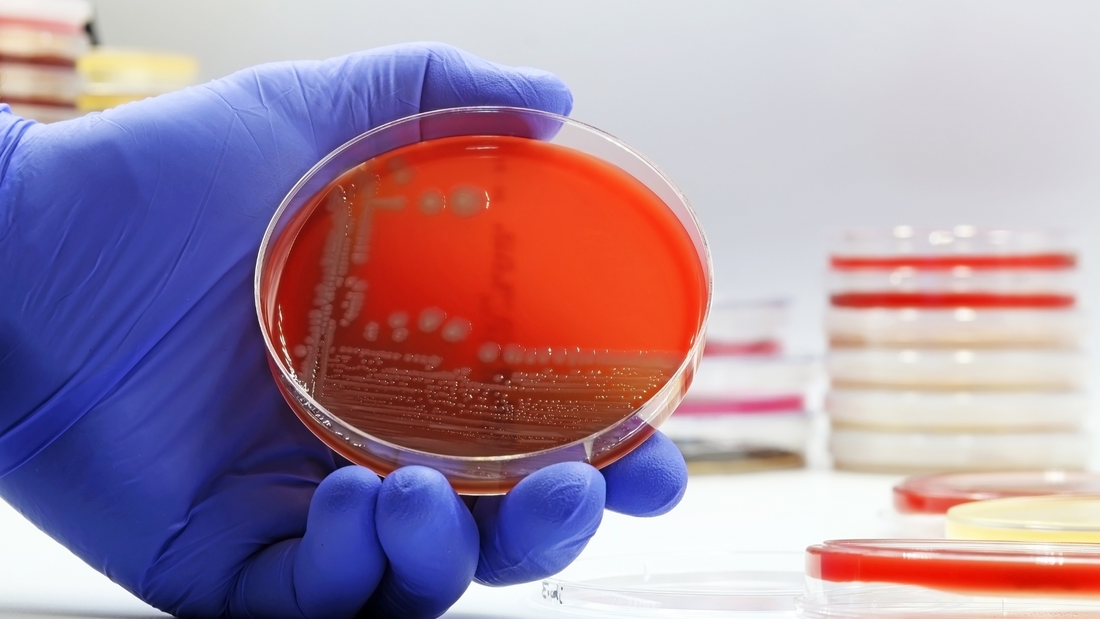
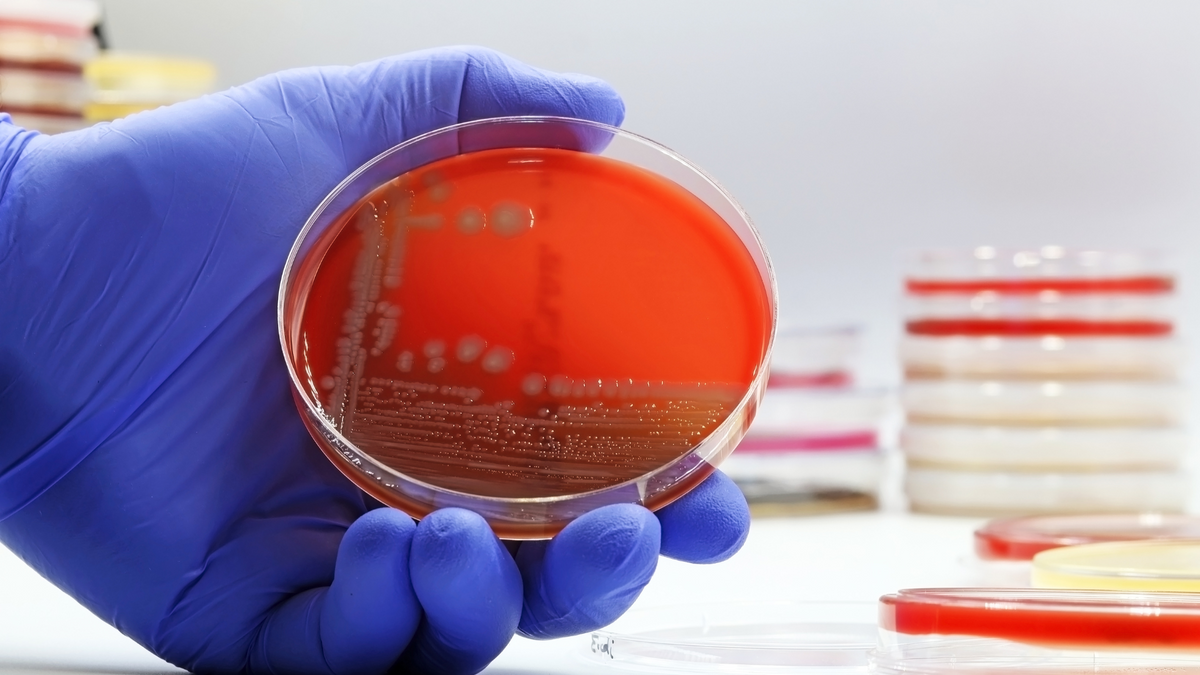
Thrush & Bacterial Vaginosis (BV) Uncovered: Dr Phillip Hay's 30 Years of Insight Every Woman Should Know

Thrush & Bacterial Vaginosis (BV) Uncovered: Dr Phillip Hay's 30 Years of Insight Every Woman Should Know
Dr Phillip Hay, a Consultant in Sexual Health at Guys and St. Thomas' NHS Foundation Trust, sits down with our founder, Dr Chiara Board, to share his expertise and clinical insights from working in sexual health for over 30 years.
Key insights:
- Thrush vs. BV: Thrush (Candida): Is a fungal infection, symptoms are thick, white discharge, itching. Non-albicans Candida may cause persistent burning. BV: Is a bacterial infection and can cause a fishy smell, thin, milky discharge. Often confused with thrush but distinct.
- Burning Sensations whilst urinating can be divided into Internal: Linked to UTIs, felt up into the bladder, while urinating. External: Caused by urine contact with irritated skin, common in thrush.
- Thrush has an oestrogen receptor, which makes it more invasive. This is why it’s less common in post-menopausal women, unless they’re using HRT, and more common in pregnancy.
-
Risk Factors:
- Thrush: High sugar intake, diabetes, pregnancy, steroid use, oestrogen contraception.
- BV: Sexual activity, lack of condom use, male circumcision.
- Diet: High sugar can worsen thrush and UTIs.
- Boric Acid: Use with caution for resistant thrush; unlicensed, not recommended during pregnancy.
Chiara: Thanks so much for joining us today, Phillip! To start, could you tell us a bit about yourself and your work?
Dr Hay: Sure! I’ve been working in sexual health for over 30 years, with a particular interest in vaginitis (inflammation of the vagina), and infections in pregnancy. About 15 years ago, I set up a recurrent vaginitis clinic, so covering conditions like recurrent BV, recurrent Candida, resistant Trichomonas (STI, caused by a parasite called Trichomonas vaginalis. It can lead to symptoms like greenish-yellow vaginal discharge, itching, redness, and irritation) and uncommon causes of vaginitis. I now run my own clinic, but I also provide free sexual health services through the NHS, helping patients navigate and manage these infections.
Chiara: What are the main differences between thrush, BV, and other conditions you see in the clinic. As it can be quite confusing, especially since discharge seems to be a common symptom for all of them?
Dr Hay: Yes, thrush is typically caused by Candida albicans and leads to a thick, curdy, white or yellow, occasionally green, discharge. It’s often itchy. Non-albicans species, like Candida glabrata, might cause less discharge but more persistent burning.
BV, on the other hand, is mainly characterised by a fishy smell and a thinner, milky discharge. Trichomoniasis can be a bit of an overlap, because you can get the fishy smell with the disturbed vaginal flora, but you also get inflammatory symptoms, so you might see greenish discharge, irritation, and redness. Sometimes it even affects the skin around the vagina.
Chiara: That’s so interesting. When patients report burning sensations, is it always linked to an infection?
Dr Hay: As a doctor, we always try to differentiate between an internal and external burning feeling. Internal burning—what we call internal dysuria—is when you feel a stinging sensation in the bladder, and all the way down the urinary tract while peeing. That’s often linked to a urinary tract infection (UTI). External burning, on the other hand, happens when urine comes into contact with irritated skin, which is common with conditions like thrush or trichomoniasis. So, when a patient says they feel burning when they pee, I always ask ‘is it all the way down from the bladder or just when it comes in contact with the skin’.
Chiara: Wow, that’s great to know – I have never been asked if my burning is internal or external. It can get quite confusing, especially now when antibiotics can also be just prescribed based on symptoms and not proper examination.
Dr Hay: Exactly. I have seen so many women with primary herpes misdiagnosed with UTIs, because they have not been properly examined, and they are reporting pain when they pee.
Chiara: Is there any way symptoms might go away on their own, or should patients always seek treatment? Can your natural microbiome ease your symptoms.
Dr Hay: I always say people used to survive in the days before antibiotics. So, most things will eventually burn themselves out. You can see patients with candida, and they say it eventually went away after a week or two of discomfort. But of course, with infections like UTIs there is a risk they can lead to complications, like kidney infections, become septic, if left untreated. It’s always better to get checked if symptoms persist or worsen.
Chiara: What are the key symptoms of chlamydia, and can it really cause infertility? What should women be aware of?
Dr Hay: For women, chlamydia is often totally asymptomatic, but when there are symptoms, they usually start at the cervix. You might see a mucus-like greenish discharge or experience bleeding after sex. If the infection spreads to the endometrium, you might see spontaneous mid-cycle bleeding. If it progresses to the fallopian tubes with pelvic inflammatory disease (PID), it may result in pelvic pain, abdominal pain, or pain during penetration.
Regarding infertility, the best studies come from Sweden, dating back to the 1960s and 70s, before chlamydia was discovered and antibiotics were available. Research from that time shows that pelvic inflammatory disease (PID) caused by chlamydia can increase the risk of infertility—5%¹ after the first episode, but up to 50% after three or more episodes. However, with modern treatments, outcomes are much more optimistic, and despite the rise in STIs, we haven't seen the same fertility impacts thanks to more effective care.
Chiara: That’s reassuring. When it comes to conditions like BV or thrush, why do they seem to recur so often for some women?
Dr Hay: In some women both conditions are occasional and sporadic. But the ones I see in my clinic are more the hardcore cases. For example, BV often comes back during menstruation every month, women with a coil and implants might also struggle more if they are getting irregular bleeding. Recurrent candida is defined as four or more episodes a year. We think it affects possibly more than 5% of the female population. Current theory is that genetics can play a role—some women may have an immune response that makes them more susceptible.
Data on BV may suggest that it is an STI, at least for the first episode, but once you are colonised with the bacteria, it can become very persistent. All our treatments do is to reduce the level, but they don’t kill them off. So, both groups often end up needing maintenance regimens to keep symptoms under control so women can get on with their lives. Both conditions may also eventually burn out, but realistically that’s years rather than months.
Chiara: That’s fascinating. Do we have any evidence for why this happens? Is the immune system adjusting or the body’s pain response changing?
Dr Hay: I wish I knew but I sadly cannot take any credit for it, if it eventually stops – but what I always say to patients is that the prevalence of these conditions seems to remain fairly constant across different age groups. For every woman who starts experiencing them, there’s likely another woman who stops. Otherwise, by age 50, nearly everyone would have these conditions.
Chiara: Great point! It seems that UTIs affect women throughout their life, however BV and thrush, while hard to measure due to women often self-treating with over-the-counter product, we’ve found that most cases tend to be in women aged 20-40. Is that what you see in your clinic?
Dr Hay: You see some UTIs in post-menopausal women. Thrush – Candida has a receptor for oestrogen making it more invasive. Less common therefore in post-menopausal women, unless women take oestrogen as hormone replacement therapy (HRT) or unless they’re diabetic. We know that sugar in your urine feeds both thrush and UTIs. However, I’ve seen a few exceptions—I’ve seen two women in her 70s who still had good oestrogen levels despite their age, which likely played a role in thrush symptoms.
Chiara: Are there other major risk factors for these conditions?
Dr Hay: For recurrent thrush, genetics can play a key role, as well as recognised risk factors like diabetes, steroid use, other immunosuppressants, and pregnancy due to higher oestrogen levels. However, most of the women I see don’t have these risk factors. That said, I always screen for diabetes when diagnosing thrush by checking for glucose in the urine—it’s a simple but effective screening test.
Chiara: What about BV? Are there specific lifestyle or behavioural factors that increase risk?
Dr Hay: Sexual activity is a big one. Research has shown that using condoms can reduce BV rates by about 20%. Interestingly, the only intervention shown to significantly lower BV prevalence is male circumcision. Studies in Africa looking at circumcision to reduce HIV transmission² found a 40% reduction in BV among female partners of circumcised men.
Research is exploring treating male partners with metronidazole and topical clindamycin cream under the foreskin. While past attempts were unsuccessful, early results are promising, though it’s still in the research phase. For UTIs, there’s little evidence that treating male partners is beneficial, except in rare cases.
Chiara: Are there any lifestyle factors, like diet or hygiene, that impact these conditions?
Dr Hay: High sugar intake is a big one—sugar in the urine can feed both thrush and UTIs. As for hygiene, traditional advice like peeing after sex to prevent UTIs is often recommended, but that’s not based on evidence from randomised trials. Similarly, there are no proper trials on douching and if it impacts recurrence of BV. The evidence is limited, but the general advice is to avoid douching, as it washes away both the good and bad bacteria. It’s also a good idea not to use shower gel or anything else in the vagina. This is especially important for preventing candida, as disrupting the lactobacilli can trigger thrush. And of course, antibiotics are a well-known trigger for thrush.
As I also mentioned earlier, BV tends to relapse with menstruation. So what I often discuss with women who take the combined pill, to explore taking the pill continuously, without breaks for periods, to help reduce the frequency of BV. Using menstrual cups may also help by preventing blood from flooding the vagina.
Coming back to diet, my colleague Gilbert Donders conducted a study in Belgium using formal glucose tolerance tests, which are typically used to screen for diabetes. He found that women with recurrent candida infections often had higher sugar levels than the control group³, even though they weren’t clinically diabetic. Women have also found that cutting back on soaps, stopping oestrogen-containing contraception, and reducing sugar and refined carbohydrates made a difference in their cases.
Chiara: That makes sense. I’ve also wondered about diet in relation to BV. Could it play a role in symptoms, like the smell?
Dr Hay: Yes, I have often wondered about diet and the degree of smell. There’s a rare condition called "fish body odour syndrome," which is an inborn error of metabolism. Women with this condition can’t properly metabolise trimethylamine because they lack the necessary enzyme. As a result, it’s secreted in their sweat and other bodily fluids, causing a strong fishy odour. I’ve never seen a case myself, but I’ve tested a few people to rule it out. The only treatment is a very restricted diet to avoid the precursors of trimethylamine. So I do wonder whether diet at least has an effect on the degree of symptoms, but no one has really researched this properly.
Chiara: Fascinating. And with BV, it seems like the microbiome plays a big role. We have noticed that some women have Gardnerella but no symptoms, while others have symptoms.
Dr Hay: Yes, it’s often an element of numbers. When Gardnerella levels are significantly elevated, that’s when BV tends to present with symptoms. There’s also ongoing research to divide Gardnerella into subspecies, some of which may be more pathogenic than others, but more research is needed.
Chiara: How do you find these conditions affect women emotionally, especially those with recurrent infections long-term?
Dr Hay: Oh, emotionally it can be terrible. They can feel stigmatised, ashamed, very unsexy, and can struggle to maintain a sexual relationship. So, some of the women I see with recurrent thrush are not able to have sex, as it is too painful. Some women with BV don’t want anyone near them, because they find the smell so offensive. I’ve had patients tell me about extremely hurtful experiences, like being in a car with someone who commented on a “terrible smell.” One of the worst cases I saw was a woman who developed severe depression and ended up being sectioned.
So, the first question, I always ask my patients, is “how is it affecting you?” but it often takes a while to build trust before they open up fully.
Chiara: And what about long-term health impacts?
Dr Hay: I keep saying that future generations will think we are mad treating BV with repeated courses of metronidazole, as I have seen women whose gut health has been really screwed by it. I use dequalinium chloride, which is a topical treatment, licensed about 6 years ago in the UK, which is more like an antiseptic than antibiotic. It seems to work for BV. Dequalinium chloride is not absorbed, so it doesn’t upset the rest of the microbiome. It has moderate anti-candida activity and so seems less likely to trigger candida than antibiotics. But overall, for sporadic cases, I provide patients with a course of treatment they can use when symptoms arise, saving them a trip to the clinic and avoiding taking a day off work. For more frequent cases, I design and recommend a maintenance schedule.
Chiara: What about boric acid? I’ve seen boric acid gaining popularity, with people on social media selling and suggesting using it on a regular basis as prevention.
Dr Hay: Boric acid is really interesting but should be used cautiously. It has potential teratogenic effects, so it’s not suitable during pregnancy. For BV, it can work, but resistance may develop quickly. Hence, my American colleagues never recommend using boric acid alone for BV; they combine it with other treatments. It’s my go-to for resistant thrush that doesn’t respond to anything else, though it should only be used for difficult cases since it’s unlicensed and we lack long-term safety data. I would definitely not recommend boric acid as a routine preventative—it should be reserved for specific, challenging cases not as a first line solution.
I believe, Boots recently started selling a product claiming to be a combined treatment for BV and thrush, and it has 20 milligrams of boric acid in it. They say not to use it while trying to get pregnant, but they don’t explicitly warn against using it during pregnancy, which surprised me. The usual dose for resistant Candida is 600 milligrams, so 20 milligrams is probably more homoeopathic.
Chiara: Thanks for sharing, loads I learnt here. When it comes to the microbiome, it’s all about keeping that balance, right? The healthier your microbiome, the less chance you have of facing problems like recurring infections.
Dr Hay: Yes, I am currently working on a small grant to look at vaginal lactoferrin, bovine lactoferrin. It is sold in Italy as Difesan. It acts like a prebiotic, supporting the growth of lactobacilli. I had one patient in her second trimester who only had Candida glabrata—a resistant strain—and Group B Streptococcus in her vaginal flora, which isn’t ideal during pregnancy. I treated the Candida with nystatin, which is safe during pregnancy but not widely available in the UK. We had to import it from Germany. I also gave her Lactoferrin, and after a month, she had a normal, healthy lactobacillus flora.
Chiara: That’s amazing! It’s interesting, though, because most of the time, no one really checks the vaginal microbiome during pregnancy.
Chiara: As we are coming to the end of the interview now, any final thoughts?
Dr Hay: It’s interesting to see all the new products coming to the market. There’s also been work on candida vaccines, but several trials have failed. Sometimes the issue is that women develop allergies to candida, and they almost need desensitisation. I’ve been looking for an immunologist who could help with that.
Chiara: Thank you so much Phillip for your time and sharing all these insights with us and our community. We are excited to continue the conversation with you in the future.

References
¹Infertility after acute salpingitis with special reference to Chlamydia trachomatis.
Svensson L, Mårdh PA, Weström L.Fertil Steril. 1983 Sep;40(3):322-9. doi: 10.1016/s0015-0282(16)47294-8.PMID: 6411496
²Effects of HIV voluntary medical male circumcision programs on sexually transmitted infections.
Mitch Matoga , Mina C Hosseinipour 1 3, Sara Jewett 2, Irving F Hoffman 1 3, Charles Chasela. PMID: 33315750 PMCID: PMC7775265 DOI: 10.1097/QCO.0000000000000696
³Impaired tolerance for glucose in women with recurrent vaginal candidiasis
Gilbert G G Donders 1, Hans Prenen, Geert Verbeke, Reinhilde Reybrouck
PMID: 12388993 DOI: 10.1067/mob.2002.126285